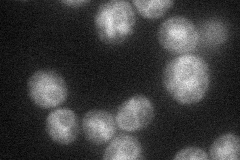
YHL028W
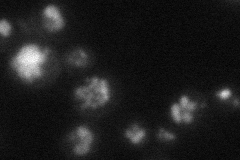
YHL028W
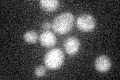
YHL028W
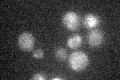
YHL028W

View description
ER membrane protein involved in the translocation of soluble secretory proteins and insertion of membrane proteins into the ER membrane; may also have a role in the stress response but has only partial functional overlap with WSC1-3
Localization:
Intensity:
Fold change:
Significance:
-
C’ GFP library in SD

below threshold16.8 -
N' NOP1pr-GFP in SD
ER39.2667 -
N' TEF2pr-mCherry in SD
vacuole19.861 -
N' NATIVEpr-GFP in SD

below threshold16.7856 -
N' TEF2pr-VC and Cyto-VN in SD

#N/A0 -
C’ GFP library in SD+DTT

cytosol15.440.91No -
C’ GFP library in SD+H2O2
cytosol15.020.89No -
C’ GFP library in Starvation Media
cytosol20.921.24No -
C’ GFP library on the background of Pup2-DaMP

below threshold -
C’ GFP library on the background of CCT mutant

below threshold14.44820.859609No
